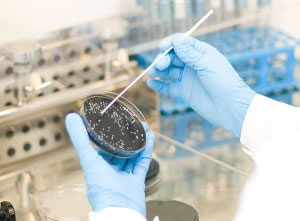
Toma de Muestras

PREVENCIÓN Y MANTENIMIENTO DE INSTALACIONES DE RIESGO DE PROLIFERACIÓN DE LEGIONELLA
La Legionella es una bacteria ambiental que vive en aguas superficiales como lagos, ríos, estanques, formando parte de la flora bacteriana. Desde este reservorio natural coloniza los sistemas de abastecimiento de las poblaciones a través de la red de distribución de agua, haciendo que llegue al sistema de agua sanitaria (fría o caliente) y a otros sistemas que requieren agua para su funcionamiento.
La Legionella contamina los circuitos artificiales del agua en concentraciones pequeñas, y en función de las condiciones ambientales se multiplican.
Las condiciones que favorecen la multiplicación de las bacterias son:
- Temperatura.- Se multiplica entre los 20ºC y 45ºC(siendo la temperatura optima entre 35-37ºC), a partir de los 50ºC no se multiplican, por debajo de 20ºC quedan en estado latente y se destruyen a 70ºC.
- Estancamiento del agua.- las zonas muertas con una velocidad baja de circulación del agua.
- La acumulación de nutrientes favorecen su crecimiento, como la presencia de lodos, materia orgánica, materia de corrosión y calcáreos..etc.
- Depósitos biológicos.- la presencia de protozoos, algas, amebas. .junto con los nutrientes forman un nicho ecológico idóneo para el desarrollo de la Legionella (la biocapa).
La Legionella tiene capacidad de crecer intracelularmente, por lo que cuando las condiciones ambientales no son favorables, se introduce dentro de otros organismos como amebas, protozoos… como mecanismo de supervivencia, lo que dificulta su destrucción. La presencia de incrustaciones calcáreas, favorecen la supervivencia, al servir de asentamiento defensivo ante las agresiones de los desinfectantes.
MECANISMO DE TRANSMISIÓN.
Cuando en la instalación existe un mecanismo que emita el agua en forma de aerosoles, la dispersión en el aire aumenta con la formación de pequeñas gotas de agua, cuando estas gotas son inferiores a 50 micras, quedan suspendidas en el aire más tiempo, pudiendo ser inhaladas por el hombre e infectarlo.
No se trasmite por ingestión (beber agua o ingerir alimentos).
No se trasmite de persona a persona, ni animales a personas.
No se tramite por el vapor de agua.
Las personas más susceptibles son personas de edad avanzadas, fumadores, las que tienen problemas inmunitarios y enfermedades crónicas etc.
NORMATIVA
La primera legislación que se publica es la de la Comunidad Autónoma de Madrid en el año 1998, como consecuencia del brote de Alcalá de Henares. Cataluña, Valencia y Galicia lo hicieron en el año 2001. Esta última con la publicación del Decreto 9/2001, de 11 de enero, por el que se regulan los criterios sanitarios para la prevención de la contaminación por Legionella en las instalaciones térmicas.
El Ministerio de Sanidad y Consumo publicó, con el respaldo de la Comisión de Salud Pública, en ese año el primer Real Decreto de prevención y control de la legionelosis, como normativa básica del Estado (Real Decreto 909/2001 de 27 de julio, por el que se establecen los criterios higiénico-sanitarios para la prevención y control de la legionelosis), que es posteriormente sustituido por el Real Decreto 865/2003, de 4 de julio, con el mismo enunciado
Los titulares de instalaciones, como pueden ser residencias de ancianos y hospitales, en los que la población es especialmente sensible a esta infección, deben tomar conciencia de la importancia de llevar a cabo un buen control.
Responsabilidad del titular de la instalación (Real Decreto 865/2003)
Artículo 4. Responsabilidad de los titulares de las instalaciones.
Los titulares de las instalaciones descritas en el artículo 2 serán responsables del cumplimiento de lo dispuesto en este real decreto y de que se lleven a cabo los programas de mantenimiento periódico, las mejoras estructurales y funcionales de las instalaciones, así como del control de la calidad microbiológica y físico-química del agua, con el fin de que no representen un riesgo para la salud pública.
La contratación de un servicio de mantenimiento externo no exime al titular de la instalación de su responsabilidad.
Artículo 13. Métodos de tratamiento de las instalaciones:
Todo el personal que trabaje en operaciones de mantenimiento higiénico-sanitario, pertenezca a una entidad o servicio externo contratado o bien sea personal propio de la instalación, deberá realizar los cursos que a tal efecto homologue el Ministerio de Sanidad y Consumo a propuesta de las comunidades autónomas correspondientes, de acuerdo con la Orden SCO/317/2003, de 7 de febrero, por la que se regula el procedimiento para la homologación de los cursos de formación del personal que realiza las operaciones de mantenimiento higiénico- sanitario de las instalaciones objeto del Real Decreto 909/2001, de 27 de julio.
Artículo 14. Infracciones y sanciones.
Infracciones graves:
g) La realización de operaciones de mantenimiento higiénico-sanitario por personal que no haya realizado los cursos a que se refiere el artículo 13 de este real decreto, como supuesto de los previstos en el art. 35.B) 1.a de la Ley General de Sanidad.

CONTROL Y PREVENCIÓN DE INSTALACIONES DE RIESGO DE PROLIFERACIÓN DE ORGANISMOS NOCIVOS POR AEROSOLIZACIÓN
DOCUMENTACIÓN A ENTREGAR AL INICIO DE LA ACTIVIDAD:
- Programa de mantenimiento higiénico-sanitario frente a la Legionella, de forma personalizada, describiendo la instalación así como su funcionamiento, plano descriptivo de la red de distribución de agua, incluyendo componentes (depósitos, puntos terminales,…) y zonas críticas etc. Se delimitará igualmente, las actuaciones a realizar en cumplimiento de la normativa vigente así como el encargado de su desarrollo. Se detectarán los puntos críticos de actuación en función del riesgo de proliferación del microorganismo en las instalaciones de riesgo.
- Copia de la documentación de A&A CONSLTORÍA. Autorizaciones sanitarias, formación de los aplicadores, etc.
- Fichas técnicas y de seguridad de los productos químicos a emplear durante el ejercicio así como periodicidad de actuaciones y plan de acción.
- Certificados de revisión, limpieza y/o desinfección de los trabajos realizados una vez ejecutados; los cuales recogerán lo indicado en la normativa:
- a) Fecha de realización de las tareas de revisión, limpieza y desinfección general, protocolo seguido, productos utilizados, dosis y tiempo de actuación. Cuando sean efectuadas por una empresa contratada, ésta extenderá un certificado según lo establecido en la normativa.
- b) Fecha de realización de cualquier otra operación de mantenimiento (limpiezas parciales, reparaciones, verificaciones, engrases) y especificación de éstas, así como cualquier tipo de incidencia y medidas adoptadas.
- c) Fecha y resultados analíticos de los diferentes análisis del agua.
- d) Firma del responsable técnico de las tareas realizadas y del responsable de la instalación.
- Hojas de registro a cumplimentar de las actuaciones periódicas y de control.
- Se explicará y formará in situ a los responsables de la empresa contratante de las actividades a llevar a cabo, periodicidad, forma de cumplimentación de los registros y archivo de los mismos.
PERIODICIDAD Y ACTIVIDADES DE DESINFECCIÓN DE INSTALACIONES
Se propondrán en función de las instalaciones de riesgo analizadas en cada entidad según lo establecido en la normativa estatal (RD 865/2003).
Los trabajos de limpieza y desinfección, serán coordinados con tiempo suficiente con el responsable de mantenimiento de la instalación o de la empresa, indicando éste el día preferible para su realización, pudiéndose hacer en agosto, festivo o en horario nocturno sin coste adicional al presupuesto.
Se realizarán desinfecciones térmicas o químicas en función de la instalación o según lo solicitado por el cliente o autoridades sanitarias ambientales.
El procedimiento tendrá en cuenta:
- El mayor ahorro de agua posible. Programando para ello, el vaciado por consumo en horas/días anteriores al tratamiento de los depósitos de agua fría de consumo humano.
- Limpieza y desinfección exhaustiva de los acumuladores de Agua Caliente Sanitaria. Para ello, se abrirán los acumuladores que dispongan de boca de acceso (boca de hombre o boca de mano) para proceder a su limpieza interior.
- Hipercloración de toda la red de distribución en los edificios. Apertura y comprobación de todos los puntos terminales de red (grifos, duchas, etc.).
- Utilización de productos químicos autorizados por el Ministerio de Sanidad para tal efecto así como inhibidores de la corrosión, con el fin de pasivar los efectos corrosivos de los mismos.
- Se coordinará con el responsable de mantenimiento del centro o con dirección el aviso de la insalubridad del agua mientras dure el tratamiento, con el fin de evitar accidentes no deseados.
- Se dotarán de todos los medios técnicos y profesionales necesarios, adecuados a las características de la instalación.
- Bomba dosificadora de cloración
- Mangueras, conexiones, etc
- Hidrolimpiadora de alta presión
- Aspirador de agua industrial
- Equipos de medición “in situ” (pH, cloro libre, total, termómetros)
- Productos químicos aptos para el tratamiento de aguas de consumo humano
- Herramienta de mano necesaria
- EPI’S de seguridad para el desempeño de los trabajos a realizar
- Escaleras
- Etc.

SERVICIO DE LABORATORIO
La importancia de la detección precoz de la presencia de Legionella es indiscutible. No solamente para llevar a cabo un rápido y certero tratamiento correctivo, que revertirá en el riesgo de los pacientes y trabajadores del centro, sino también para iniciar la búsqueda de las posibles fuentes contaminantes o de los motivos que originaron el crecimiento de la bacteria.
La característica más importante de detectar a tiempo la bacteria Legionella es la concentración, el tiempo y el espacio donde se aísle. Es por ello, que A&A propone una distribución minuciosa de análisis de agua en el edificio, de tal forma que se pueda cubrir diferentes puntos distantes entre sí de forma organizada y lógica.
Determinación de Legionella según norma ISO 11731 cultivo, cuantificación y enumeración:
TOMA DE MUESTRAS
TOMA DE MUESTRAS- A realizar por personal técnico cualificado propio, siguiendo el procedimiento establecido en el Real Decreto 865/2003, anexo 6.
- Utilización de torundas, envases estériles y neutralizado mediante tiosulfato sódico incorporado.
- Identificación de las muestras, mediciones in situ de temperatura y cloro libre residual (para agua sanitaria).
- TRANSPORTE
- Transporte hacia el laboratorio en vehículo de empresa (no mensajería) evitando temperaturas extremas (refrigerado) y en el tiempo mínimo (máximo 24 horas).
- ANÁLISIS DETERMINACIÓN DE LEGIONELLA
- Laboratorio acreditado, conforme sistema de Gestión de Calidad ISO 9001:2008
- EMISIÓN DE INFORME Y VALORACIÓN DE RESULTADOS
- Entrega personalizada y confidencial de resultados. Adelantando los mismos en formato electrónico y posterior informe físico.
- Información de los resultados obtenidos así como las actuaciones a realizar conforme a la legislación vigente.
- PERIODICIDAD DE LA TOMA DE MUESTRA Y Nº MUESTRAS RECOGIDAS: se establecerá en función de las instalaciones de riesgo encontradas en los centros y/o indicadas por las Autoridades Sanitarias.







